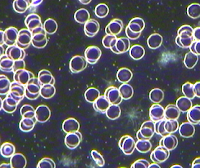

The most simple and effective ways you can improve your health... this is my style in approaching change. Get the mind right and the rest will follow.
1. Have a vision.
2. Be your own best friend.
This is the hardest part! The only way you can bring good things into your life, including health, happiness, abundance and looks is by being a better friend to yourself and to learn self love and acceptance. You can always rely on your bestie to pick you up when you're feeling down, encourage you at the right times and also give you sound and practical advise when needed. Have you ever thought about doing all these things but for you? Imagine telling yourself how well you're doing and how proud you are... how much more could you achieve with a best friend at your side the whole time? It's a hard habit to break and it takes time and repetition but many of us have the inner negative voice, the constant critic. Many of us weren't raised with continuous positive appraisal so we have to consciously support ourselves, no matter what.
3. You are what you eat
(and what you think and feel). As the old saying goes but we are of course much more than that. Let's view your health down to a cellular level. All the cells of your body, skin, liver, reproductive and all the rest need nutrition directly from your food. Eating unhealthy foods will cause malnutrition and less than optimal cellular health. Wherever your weakest link is, for example skin problems, your skin cells are weakened and functioning poorly because your diet doesn't support the cellular health. You can't eat deep fried foods, soft drink and sugary sweets and expect your cells to be happy? Eating highly nutritious foods gives your cells, system and body everything it needs to be healthy, beautiful and strong. Choose organic or grow some of your own produce, your body will love you for it!
Below are dark field microscopic images of red blood cells the first image shows how round, symmetrical and ordered the blood can be when properly looked after (the little ghost in the top right corner is a white blood cell). The second image is showing inflammation, most likely caused by diet. Sticky, poorly formed red blood cells plus spidery webs in the background indicating liver inflammation (acute phase proteins).
Healthy red blood cells viewed under dark field microscope
Red blood cells showing signs of inflammation and a sluggish liver
That saying totally resonates with me. I always say get the diet right first then focus on including or improving your exercise regime. Improving your diet will make you feel instantly better, less gut ache, clearer head and better mood. Then it's easy to get moving. Choose what exercise suits your lifestyle and body type. Men can do more strenuous exercise while women have to cater for their cycle. If you already exercise consider what you can do to "tweak" it.
I personally don't go to the gym. I prefer getting outside (even if it's drizzly) because the sunshine and fresh air do more for me than just tone my muscles. I like a simplistic approach to my routine and I prefer the shape and "feel good" affects it has on my body. Regular hiking and beach walks with my dogs to clear my head and keep me fit is the perfect way for me.
My other love is yoga, this is where exercise gets a little deeper. We view exercise as something to do only for the outside of our body, change your perspective and use it as a way to tone the inside. Yoga affects the major organs (liver, kidneys, lungs) and glands (thyroid, pituitary) of the body depending on the asana/ position. Consider having toned organs as well as toned muscles. Just because we can't see them, doesn't mean we shouldn't exercise them as well. The key to a healthy looking body is to have healthy organs as well.
5. Deep, restful, sleep.
When we're awake, natural damage occurs to our body, when we're asleep we are healing. Without sleep our bodies cannot repair any damage that has happened throughout the day. Also, we need a bit of down time to rest our minds. It's not just the quantity of sleep that matters but the quality. Do you fall asleep easily? Do you wake up during the night? Do you suffer from bad dreams?Make sleep a priority, keep regular times and enjoy a cat nap here or there when opportunity arises. Traditional Chinese Medicine suggests yang (awake) needs to be equal to yin (sleep) for ideal balance. Ways to encourage yin to our lifestyle is by listening to quiet music in the evenings, turning off the TV, dimming the lights, using aromatherapy, herbal tea and having a nice bath or shower before bed time. Make it a ritual.
When the sun sets, it's time to rest or at least start slowing down. Our circadian rhythm (sleep wake cycle) is governed by the sun. Many people aren't exposed to the sun throughout the day, or even when awake. People who work nights have to do the best they can and ensure enough rest in the day time. Bright lights interfere with the sleep cycle, so as the sun starts to set, turn on the lamps for a better nights sleep.
Drink pure water and drink plenty of it everyday, preferably in the first part of the day. Give your water more life by adding thinly sliced fruit, fresh herbs and a pinch of Himalayan or Celtic sea salt to put the minerals back in.
Drink green, white and herbal teas everyday. I gave up drinking coffee a few years ago. I came to the terms with the fact my body just hated it. I would get a huge adrenalin rush then just as quickly become irritable and tired and no matter how much water I drank, I couldn't seem to rehydrate. Some people are just caffeine sensitive. So, I started drinking only organic green tea and other herbals. I've totally cut coffee out and I've felt a million times better. More energy, better mood, better sleep... what else could you ask for?
Green tea has a decent amount of caffeine still but I can drink it all day and I only feel good from it, no negative benefits and I think it's one of my health secrets. The thing that really makes the difference is drinking the right type of fluid.
Drink everyday and you will feel amazing....
Water
Green tea
White tea
Herbal teas
7. Use natural cosmetics.
What you apply on your skin and use around your house will be absorbed by your body and your hardworking liver will have to find a way to remove it. There are so many genuine natural cosmetic companies with competitive pricing, there is no excuse not to by eco-friendly products. When it comes to natural beauty you have been tricked into thinking only chemical based products work. Herbal extracts, essential oils and organic nut/ seed butters contain naturally occurring chemical constituents that have different therapeutic effects. Having said this the potency of ingredients need to be considered when purchasing natural goods.
Be wary of environmental pollutants. The detergents, sprays, paints etc do have implications on our health but also the environment. Make a choice to use biodegradable products around the home and expose yourself less to unnecessary chemicals.
9. Manage your stress.
Without stress, we wouldn't get up in the morning. We need a little to get our adrenal glands stimulated and have the motivation to get the day on the way. Too much stress then our adrenals become fatigued and we're wishing to finish the day before it has even started! We all have stress but how much do you stress? How much do you have to stress about? Your work, relationships and health demand much attention these days. Evaluating the choices you've made, finding solutions and doing the very best you can is all you can ask for. Think seriously about where you place your value (money, relationships, health, happiness) and either restructure your arrangements or make the most of what you have.
It's so important that during times of stress you look after yourself. I've been there and done that (putting yourself last because of pressure and life situations) and I know how much easier coping with everything is when you do the right thing by you. Your mind is clear and have a stronger spirit and that's all you need to get through the rough times.
You can be stressed and not realise it. It's only when you're centered and at a point in life that you can reflect on just how much pressure you were under at the time. 10. Be in control of your health.
Be in control and be aware of your health but seek professional guidance when needed. Get medical health checks done and tick all the boxes. See a naturopath, herbalist or nutritionist regularly to help evaluate the quality of your life, or if you need any assistance. Just make sure whoever you see has been referred and has a good reputation. Not all naturopaths are created equal, just as not all doctors, dentists or chiropractors are created equal too.
Be informed about current health news but don't be a slave to it, question everything!